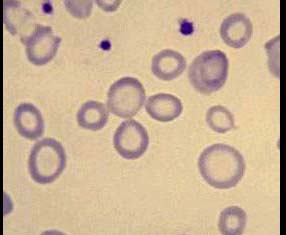

贫血患者血片如图,运铁蛋白饱和度0.12,最可能的诊断是()
A.再生障碍性贫血
B.缺铁性贫血
C.慢性感染性贫血
D.铁粒幼细胞性贫血
E.自身免疫性溶血性贫血
参考答案与解析:
-
相关试题
-
贫血患者血片如图,运铁蛋白饱和度0.12,最可能的诊断是()<img border="0" style="width: 286px; height: 235px;&
-
[单选题]贫血患者血片如图,运铁蛋白饱和度0.12,最可能的诊断是()A.再生障碍性贫血B.缺铁性贫血C.慢性感染性贫血D.铁粒幼细胞性贫血E.自身免疫性溶血性
- 查看答案
-
贫血患者血片如图,运铁蛋白饱和度0.12,最可能的诊断是()
-
[单选题]贫血患者血片如图,运铁蛋白饱和度0.12,最可能的诊断是()A . 再生障碍性贫血B . 缺铁性贫血C . 慢性感染性贫血D . 铁粒幼细胞性贫血E . 自身免疫性溶血性贫血
- 查看答案
-
贫血患者血片如图,运铁蛋白饱和度0.12,最可能的诊断是()
-
[单选题]贫血患者血片如图,运铁蛋白饱和度0.12,最可能的诊断是()A .再生障碍性贫血B .缺铁性贫血C .慢性感染性贫血D .铁粒幼细胞性贫血E .自身免疫性溶血性贫血
- 查看答案
-
根据图像,最可能的诊断是()<img border="0" style="width: 312px; height: 235px;" src="
-
[单选题]根据图像,最可能的诊断是()A.肺气肿B.慢性支气管炎C.气胸D.纵隔气肿E.肺转移瘤
- 查看答案
-
阅读下列程序:<br /><img border="0" style="width: 235px; height: 235px;" src=&
-
[单选题]阅读下列程序:程序运行后,单击命令按钮后的输出结果是( )。A.234B.345C.567D.356
- 查看答案
-
根据超声图像所示,最可能的诊断是<img border="0" style="width: 374px; height: 286px;" src=&quo
-
[单选题]根据超声图像所示,最可能的诊断是A.肾结石B.肾感染性疾病C.肾结石并肾积水、感染D.肾积水E.肾盂旁囊肿
- 查看答案
-
女,62岁,头痛,精神焦虑,CT检查如图,最可能的诊断为()<img border="0" style="width: 286px; height: 347px;&
-
[单选题]女,62岁,头痛,精神焦虑,CT检查如图,最可能的诊断为()A.正常脑CTB.苍白球钙化C.腔隙性脑梗死D.脑出血E.脑萎缩
- 查看答案
-
患者男,50岁,胸背剧痛1周余,CT如图,最可能的诊断是<img border="0" style="width: 286px; height: 212px;&qu
-
[单选题]患者男,50岁,胸背剧痛1周余,CT如图,最可能的诊断是A.主动脉弓真性动脉瘤B.主动脉弓假性动脉瘤C.主动脉弓夹层动脉瘤D.左上肺癌并侵犯主动脉弓部
- 查看答案
-
患者男,50岁,胸背剧痛1周余,CT如图,最可能的诊断是<img border="0" style="width: 286px; height: 212px;&qu
-
[单选题]患者男,50岁,胸背剧痛1周余,CT如图,最可能的诊断是A.主动脉弓真性动脉瘤B.主动脉弓假性动脉瘤C.主动脉弓夹层动脉瘤D.左上肺癌并侵犯主动脉弓部
- 查看答案
-
<img border="0" style="width: 286px; height: 28px;" src="https://img.zha
-
[单选题]A.5mmB.10mmC.15mmD.20mmE.25mm
- 查看答案
